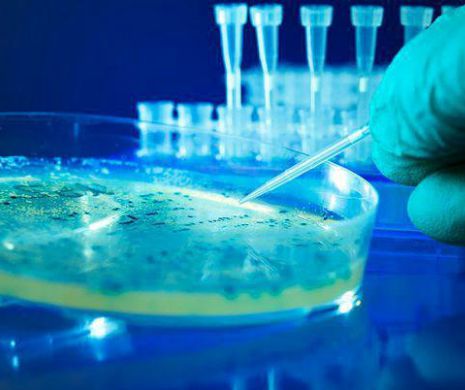

Tratamentul pentru hepatita cronică virală C vine mai devreme
- Georgiana Ioni ţă
- 30 august 2018, 02:17
De la 1 septembrie asiguraţii vor avea acces la trei noi scheme de tratament interferon free pentru hepatita cronică virală C, informează Casa Naţională de Asigurări de Sănătate.
„Asiguraţii vor avea acces cu 30 de zile mai devreme, decât termenul prevăzut iniţial, la trei scheme de tratament, altfel spus o abordare mult mai personalizată a tratamentului. (...) Având în vedere decizia de astăzi a Guvernului prin care aceste tratamente au fost introduse în lista medicamentelor, noile contracte vor intra în vigoare de la data de 1 septembrie”,transmite CNAS.
13.000 de pacienți eligibili
Pentru aceste trei variante de tratament sunt eligibili 13.000 de pacienţi - 12.100 cu fibroză F1, F2, F3 şi F4 (ciroză compensată), 750 cu fibroză F4 şi ciroză decompensată, 100 cu insuficienţă renală cronică aflaţi în dializă, indiferent de gradul de fibroză, 50 cu transplant hepatic, indiferent de gradul de fibroză.
Odată cu creşterea numărului de pacienţi eligibili, faţă de precedentele etape de tratament fără interferon, s-au înființat şi mai multe centre pentru tratare, ajungându-se la 1 3. Informaţii despre oraşele unde se regăsesc centrele de tratament se găsesc pe pagina www.cnas.ro.











